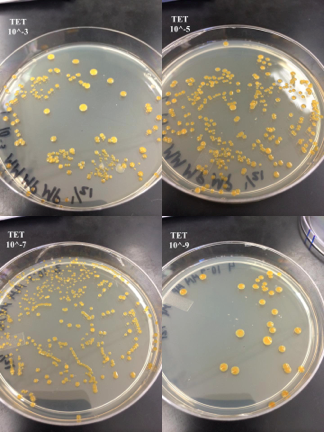

User:Megan Piccirillo/Notebook/Biology 210 at AU
Zebrafish Development Lab: The Effect of Caffeine on Zebrafish Embryos
Introduction: Studying of the embryology of an organism provides insights into its phylogenetic relationships and allows scientists to better understand the growth patterns and development milestones of an organism (Bentley, 2015). In the following lab, we used the model organism, zebrafish, to test a variable environmental factor, to see whether it would influence the growth and development of zebrafish embryos. The tested chemical was caffeine.
Hypothesis and Predictions: I hypothesis that zebrafish embryos that are exposed to caffeine will develop at a slower rate than zebrafish embryos developing in pure, freshwater. I predict that embryos developing in the caffeine solution will have stunted growth and once hatched, will have higher heart rates compared to the control group.
Materials and Methods: 20 mL of a 25mg/L caffeine solution was placed into a Petri dish using a seriological pipette and a pipette-aid. 20 mL of pure Deerpark water was added to a second Petri dish. 20 zebrafish embryos were placed into each Petri dish. Tape was used to secure the tops of the Petri dishes and the dishes were placed in an air-tight bin to reduce evaporation. Dissection microscopes and compound microscopes were used to view the zebrafish and make observations.
Observation Day 1: Beginning of Experiment, February 18th
Control group (in Deerpark water):
Alive (#): 20
Dead (#): 0
Stage of Development: 13-somite stage, and 25-somite stage, 2 at the 24 hour stage
Size: not measured
Movement: Rotating within the egg shell
Other observations: Obvious black eye sockets, eggs are transparent
Test group (in caffeine solution):
Alive (#): 20
Dead (#): 0
Stage of Development: 13-somite, 17-somites, and 1 at the 20-somite stage
Size: not measured
Movement: Rotating within the egg shell
Other observations: Obvious black eye sockets, eggs are transparent
Observation Day 2: Friday, February 20th
Materials and Methods: 10mL of Deerpark water was removed from the Petri dish and 12mL was replaced in order to account for evaporation. This was done for the caffeine solution as well.
Control group (in Deerpark water):
Alive (#): 19
Dead (#): 1
Stage of Development: None hatched, 48 hour stage (H/I in the below chart)
Size: Varied, specimens approx. 1.15mm
Movement: No movement
Other observations: Two specimens were observed under a compound microscope. Specimen #1was not moving and had mold spores growing on it. This was not surprising since the embryo that died was covered in mold. Specimen #2's blood was obviously circulating and the embryo's width (diameter of the egg) was 1.15mm and its eye diameter was .20mm.


Test group (in caffeine solution):
Alive (#): 14
Dead (#): 6
Stage of Development: None hatched, 48 hour stage (H/I in the above chart)
Size: Varied, specimens approx. 1.15-1.20mm
Movement: No movement
Other observations: Two specimens were observed under a compound microscope. Both were transparent, and the eye sockets were bulging. Speciman #1 measured 1.15mm for its width (diameter of the egg) and the eye diameter was .25mm. Specimen #2 measured 1.20mm for its width (diameter of the egg) and .20mm for its eye diameter.

Observation Day 3: February 23rd
Control group (in Deerpark water):
Alive (#): 19
Dead (#): 0
Stage of Development: 17 larvae, 2 unhatched with developing tails
Size: Approx. 3.25-4.00mm, 2 approx. 3.15-3.55mm
Movement: Some eye movement and responds to disruption of environment.
Other observations: Remain on edge of the Petri dish and seem to stay calmer when exposed to light.
Test group (in caffeine solution):
Alive (#): 13
Dead (#): 1
Stage of Development: Larvae
Size: approx. 3.40-4.00mm
Movement: Very hyperactive, more apt to move without disruption to environment, pivotal movements, dart-like reactions to taps on the dish.
Other observations: Light doesn't seem to stun the movements as much.
Observation Day 4: February 25th
Methods and Materials: 15mL of the Deerpark water was removed and 15mL of fresh Deerpark water was replaced. The same was done for the caffeine solution. TO measure the heart rate, we conducted 3 trials of the zebrafish. The heart rate was counted for 10 seconds and recorded. After the 3 separate 10 second intervals and measurements were completed, the heart rate was converted into beats per minute by multiplying by 6.
Control group (in Deerpark water):
Alive (#): 17
Dead (#): 2
Stage of Development: Larvae
Size: Varied, specimens approx. 3.50-4.00mm
Movement: Darting movement
Other observations: 3 specimens were observed under a compound microscope. Specimen #1 had a body length of 3.50-3.75mm, Specimen #2 had a body length of 3.75-4.00mm and an eye (socket) diameter of .125-.15mm. The third specimen was particularly interesting because it appeared deformed- with an arch in its body/spine and it appeared to be swimming on its side. This specimen was preserved using tricaine and paraformaldehyde (Bentley, 2015). Measurements were challenging to capture because of the movement.
'

Test group (in caffeine solution):
Alive (#): 12
Dead (#): 1
Stage of Development: Larvae
Size: Varied, specimens 2.75-3.00mm
Movement: All swimming with darting movements. When still, the fish appeared to be vibrating or shaking.
Other observations: Under a compound microscope, 2 zebrafish larvae were observed. Specimen #1 had a body length of approx. 3.00mm and an eye socket diameter of approx. .25mm. Specimen #2 had a body length of approx. 2.75mm. The heart rate of the 2nd specimen was approximately 166 beats per minute. One of the live zebrafish was removed and preserved for later observation.
Observation Day 5: February 27th
Materials and Methods: 10mL of Deerpark water was removed from the Petri dish and 10mL of Deerpark water was replaced. This was also done for the caffeine solution. The Petri dishes were also changed due to cracks in the lids. The solution and embryos were transferred using a pipette.
Control group (in Deerpark water):
Alive (#): 16
Dead (#): 1
Stage of Development: Larvae
Size: Varied, specimens 3.50-4.00mm
Movement: Some demonstrated no movement until disturbed.
Other observations: Three specimens were observed under a compound microscope. Specimen #1 had a body length measuring approx. 3.50-4.00mm . The second specimen had a body length of approx. 3.75-4.00mm and an eye socket diameter of .125-.15mm. The third specimen had an eye socket diameter of approx. .125 mm. However, exact measurements were challenging to attain due to movement.
Test group (in caffeine solution):
Alive (#): 7
Dead (#): 5
Stage of Development: Larvae
Size: Varied, specimens 3.00-4.00mm
Movement: Flittering and jittery when not swimming, but darting movements when swimming.
Other observations: Four specimens were observed under a compound microscope, 2 of these specimens were dead and 2 of these specimens were alive. Specimen #1 (ALIVE) measured 4.00mm for its body length and was very jittery and shaky. Specimen #2 (ALIVE) measured 3.00-3.25mm in length and its eye socket diameter was approx. .125mm. Specimen #3 (DEAD) measured 3.875mm, and the head and eyes were not obvious and seemed to be undeveloped or underdeveloped. Specimen #4 measured 3.50mm for its body length, but had an obvious bead and eye structures .
Observation Day 6: March 2nd
Control group (in Deerpark water):
Alive (#): 16
Dead (#): 0
Stage of Development: Larvae
Size: approx. 3.50-4.00mm
Movement: More controlled movements in response to tapping the dish and water disturbances.
Other observations:
Test group (in caffeine solution):
Alive (#): 1
Dead (#): 6
Stage of Development: Larvae
Size: Approx. 4.00mm
Movement: Hyper reactions when disrupted, though still until disruption occurs. Active eye movement.
Other observations: Despite 6 deaths in a short period of time, there is no evidence/trace of the other fish in the solution. The variable group seems to have darker dots on its spine than the control fish.
Observation Day 7: March 4th, final day of experiment
Control group (in Deerpark water):
Alive (#): 10
Dead (#): 6
Stage of Development: Larvae
Size: Varied, specimens 3.25-4.125mm
Movement: Not easily startled. Swimming but not it darted motions.
Other observations: Four specimens were observed under a compound microscope, 2 of which were alive and 2 of which were dead. Specimen #1's (ALIVE) body length measured 3.75mm and its eye diameter measured .175mm. Specimen #2's (ALIVE) body length measured 3.25mm and its eye diameter measured .25mm. Specimen #3 (DEAD) measured 3.75mm and Specimen #4 (DEAD) measured 4.125mm.
Test group (in caffeine solution):
Alive (#): 1
Dead (#): 0
Stage of Development: Larvae
Size: 4.125mm
Movement: Appears shaking, jittery, and exhibits a pulsing movement when not swimming. Easily startled into darting movements.
Other observations: The last surviving larvae in the variable group was observed under a compound microscope and its body length measured 4.125mm and its eye diameter measured .20mm.
Tables:

Table 1 above shows the number of zebrafish alive for each group, at the time of observation, as well as the developmental stages of the embryos at each observation.

Table 2 above shows the measurement ranges for the observed zebrafish samples from each group.
Conclusions: Based on the observations made during this experiment and the collected data, it seems that an environment with caffeine does not efficiently support zebrafish life, as only 1 zebrafish made it the end of the experiment. Furthermore, the collected data regarding movement indicates that caffeine impacts zebrafish's central nervous system and locomotion. However, due to human error during this experiment, it is challenging to assess the relationship of caffeine with zebrafish growth, especially because movement made accurate measurements a challenge. Overall, future experiments could further test caffeine's effects on the development of the central nervous system (such as neurons and the brain) and on the heart, since caffeine is a stimulant.
Sources:
Bentley, M., Walters-Conte, K., and Nancy K. Zeller. 2015. A Laboratory Manual to Accompany: General Biology II. Department of Biology, American University: Washington D.C.. 50-62.
-MP
Lab 3: Microbiology, continued
Introduction: During lab 3, we prepared a PCR to amplify the 16S rRNA gene in order to identify bacteria within our transect by DNA sequence, rather than only by microscopic observations. During week 3, we prepared the PCR and during week 4 we used these PCR products to run an agarose gel. Finally, on week 7, we received the DNA sequence and were able to identify the bacteria from this information.
Materials and Methods: To set up the PCR we transferred a sample of our bacteria into a tube containing 100μL of water. For 10 minutes, the tube was incubated at 100°C and after these 10 minutes, we spun the tube in a centrifuge for 5 minutes at 13,400 rmp. In a PCR tube, we added 20μL of a pre-prepared water/primer mixture and mixed it to dissolve the PCR bead. 5μL of the supernatant from the centrifuged tube was added to the tube containing the primer and PCR mixture. This was repeated for two bacterial samples, one from the agar nutrient only plate and one from the agar nutrient with tetracycline plate (Bentley, 2015).
Results:

Above is a picture of our gel electrophoresis, conducted on February 4th, 2015.
We received the DNA sequencing of the 16S rRNA gene this week on February 25th, which was sequenced by an outside agency. The 16S rRNA gene was chosen for sequencing because it is a found in all prokaryotic bacteria and therefore is a reliable source of information regarding a bacteria's genetics and characteristics (greengenes.lbl.gov). Using online translation tools, we determined that the two bacteria identified were Chryseobacterium sp. THG A18 and Klebisella variicola strain A6128. Chryseobacterium are characterized by being gram negative, nonmotile, and rod shaped. Furthermore, on growth media colonies appear yellow or orange and shiny (Vandamme, 1994). This is consistent with our observations for the Agar nutrient with tetracycline plate (10 ^-9). Klebsiella variicola are gram negative, and the genus is characterized by rod shaped bacterium. The study indicates that K. variicola are naturally resistant to ampicillin and carbenicillin, but there was no indication of resistance to tetracycline (Rosenblueth, 2004). This description seems most consistent with our bacterial sample from the Agar nutrient plate (10^-3).
Sources:
Bentley, M., Walters-Conte, K., and Nancy K. Zeller. 2015. A Laboratory Manual to Accompany: General Biology II. Department of Biology, American University: Washington D.C.. 25-32.
Greengenes.lbl.gov - Aligned 16S rDNA data and tools. (n.d.). Retrieved February 27, 2015, from http://greengenes.lbl.gov/cgi-bin/JD_Tutorial/nph-16S.cgi
Rosenblueth, M., Martinez, L., Silva, J., & Martinez-Romero, E. 2004. Klebsiella variicola, A novel species with clinical and plant-associated isolates. Systemic and Applied Microbiology. 27: 27-35.
Vandamme, P., Bernardet, J.F., Segers, P., Kersters, K., & Holmes, B. 1994. New Perspectives in the Classification of the Flavobacteria: Description of Chryseobacterium gen. nov., Bergeyella gen. nov., and Empedobacter nom. rev." International Journal of Systemic Bacteriology.44: 827-831.
Lab 5: Invertebrates
Objectives: To understand the importance of invertabrates and to learn how simple systems evolved into more complex systems (Bentley, 2015).
Introduction: Along with protists, bacteria, and plantae, invertebrates are found in ecosystems and serve important roles in the food chain. Invertebrates are diverse, consisting of 14 phyla, which include millions of species (Bentley, 2015). Using the samples collected from a Berlese Funnel, we examined a sample of invertebrates collected from our transect. Furthermore, the diversity of invertebrates is evident from their range of features, including motility, embryonic development, and the organization of germ layers. I hypothesize that there will be a variety of invertebrates from different classes within our transect's sample.
Materials and Methods: We collected leaf litter from throughout the transect. We then poured 25mL of a 50% ethanol/ 50% water solution into a 50mL conical tube. This filled tube was attached, with tape, to the bottom of a funnel. A plastic screen was fitted into the bottom of the funnel, to ensure that leaf litter would not fall through. The screen was secured with tape. The collected leaf litter was placed on top of the screen inside of the funnel and the connection between the tube and the funnel was parafilmed to ensure that the solution did not evaporate. Last, the setup was placed under a 40 watt lamp and the entire setup was covered with foil. The setup was left untouched for one week (Bentley, 2015). This week, to observe the sample of invertebrates collected from the Berlese Funnel, we collected 10-15mL of the liquid from the tube. Two samples were taken, one from the top of the tube and one from the bottom of the tube. The samples were poured into a petri dish and we observed the samples using a dissection microscope. To identify the collected invertebrates, we used a picture key (Bentley, 2015).
Data and Observations: Below is a table of the data we collected based on our Berlese funnel sample.

Another classification within the animalia kingdom are vertebrates. Within an ecosystem such as a garden, I would expect to find rabbits (Chordata, Mammalia, Lagomorpha, Leporidae, Oryctolagus), squirrels (Chordata, Mammalia, Rodentia, Scuiuridae), fox (Chordata, Mammalia, Carnivora, Canidae, Vulpini), sparrows (Chordata, Aves, Passeriformes, Passeridae) and crows (Chordata, Aves, Passeriformes, Corvidae, Corvus). However, from my observations (based on animal feces found), the only vertebrate evident in this transect were rabbits. Therefore, this data is largely a simulation and hypothetical. Below is a food web which combines the observations from this lab (vertebrates and invertebrates) and previous labs (plantae, fungi, bacteria, protisits).

Conclusion and Next Steps: From the food web above, it is clear that each organism plays an important role in this ecosystem. Not only biotic factors are important though; abiotic factors are vital as well to the health and homeostasis of an ecosystem. While this food web may not be completely accurate for our transect, it depicts what such a system might look like. For future experiments, perhaps cameras could be left out to see what vertebrates come by during the day and at night, rather than relying on a few short visits to the area.
Sources:
Bentley, M., Walters-Conte, K., and Nancy K. Zeller. 2015. A Laboratory Manual to Accompany: General Biology II. Department of Biology, American University: Washington D.C.. 43-49.
Parr, C. 2005. "Corvus brachyrhynchos" (On-line). Animal Diversity Web, University of Michigan. (18 Feb. 2015).
Lab 4: Plantae and Fungi
Objectives: To understand the characteristics and diversity of plants and to appreciate the function and importance of fungi. (Bentley, 2015)
Introduction: Over the past three labs, we have observed the biodiversity from our transects. During this lab, we collected plant and fungi species from within our transect and characterized them in order to better understand the biodiversity within our transect. Because plants and fungi are vital parts of our nitrogen and carbon cycles, it is important to understand the presence of these species within our transect. I would hypothesize that while there will be diverse types of plant and fungi within our transect, the plants will maintain some similar characteristics. However, the fungi will have different characteristics from the plantae based on the phylogenetic tree of life on Earth.
Materials and Methods: We collected five plant samples from our transect in order to study the plant and fungi life within this area. We used both a dissection microscope and a compound microscope in order to better view the organisms and understand their cellular structure.
Data and Observations: The leaf litter in our transect was scattered and in the vegetation boxes, was concentrated under the living plants. However, the pine needles were piled near the fence. During our visual observation of the transect, no seeds were evident. Below is a table of the five plant/fungi samples we collected.

The table below contains a picture of each specimen.

Conclusion and Next Steps: From our observations, seen in the above table, each specimen had at least one characteristic that was the same as another specimen. For example, samples 1, 4 and 5 were all angiosperms, while samples 2 and 3 reproduced through spores. I hypothesized that the samples from our transect would maintain some similar characteristics, which appears to be true. However, it is not entirely clear why this is. Next lab, we will view the products of our Berlese Funnel, in order to further understand the biodiversity of our transect through invertebrates.
Bentley, M., Walters-Conte, K., and Nancy K. Zeller. 2015. A Laboratory Manual to Accompany: General Biology II. Department of Biology, American University: Washington D.C.. 33.
Lab 3: Microbiology and Identifying Bacteria with DNA Sequences
Objectives: To understand the characteristics of bacteria, to observe antibiotic resistance, and to understand how DNA sequences are used to identify species (Bentley, 2015)
Introduction: Last week we prepared eight separate serial dilution plates in order to allow bacteria from our transect, a community garden, to grow. Four of the plates contained nutrient agar, at four different dilutions (10^-3, 10^-5, 10^-7, and 10^-9), and four plates contained both nutrient agar and tetracycline, also at four different dilutions (10^-3, 10^-5, 10^-7, and 10^-9). This week, we used these eight plates to observe the bacteria that came from our transects and to understand the characteristics of bacterial growth, as well as the role of antibiotics. I hypothesize that there will be less bacterial growth on the plates with tetracycline than those without the tetracycline when comparing plates with the same serial dilution concentrations.
Materials and Methods: Last week, we prepared the agar and agar with tetracycline plates. 10 mL of broth was put into each of the four, labeled tubes labeled (10^-2, 10^-4, 10^-6, or 10^-8). After mixing the Hay Infusion to ensure homogeneity, 100μL of the Hay Infusion was added to the 10mL of broth in the 10-2 tube. From the 10-2 tube, 100microL was taken of the broth/Hay Infusion mixture and placed into the 10-4 tube using a micropipette. From the 10-4 tube, 100microL was taken of the broth/Hay Infusion mixture and placed into the 10-6 tube using a micropipette and from the 10-6 tube, 100μL was taken of the broth/Hay Infusion mixture and placed into the 10-8 tube using a micropipette. This process reduced the concentration of the Hay Infusion in each tube. Next, we plated the serial dilutions by taking 100microL of the broth/Hay Infusion mixture from the 10-2 tube and carefully spreading it onto the nutrient agar plate. This step was repeated seven more times, for a total of 8 plates, 4 of which contained only nutrient agar and 4 of which contained nutrient agar and tetracycline. Each broth/Hay Infusion tube (10^-2, 10^-4, 10^-6, or 10^-8) was used twice, once for a nutrient agar plate and once for a nutrient agar with tetracycline plate. Below is a table showing the corresponding tubes and plates with the proper concentrations. The 8 plates were then left to incubate at room temperature for one week, laying side-up on a rack (Bentley, 2015).
This week, we used a compound microscope (at 10x, 40x and 100x, oil immersion) to view and make observations about four samples of the bacteria growth on four different plates. To observe the samples under a microscope, we made wet mounts. To do this we first sterilized a loop over a flame and scraped a small amount of bacteria. Placing a drop of water on the slide, using a pipette, we mixed the bacteria on the loop with the water and placed a cover slip on top (Bentley, 2015).
Another procedure completed this week was the gram stain. After sterilizing a loop, taking a sample of the bacteria, and placing it on the slide, we used a gas flame to fix the bacteria sample to the slide. Once dry, we covered the bacteria with crystal violet for one minute and rinsed with water. We then covered the bacteria with Gram’s iodine mordant for one minute and again rinsed with water. We then covered the bacteria smear with 95% alcohol for 10-20seconds and rinsed with water. Finally, we covered the bacteria with safranin stain for 20-30 seconds and then rinsed again with water. We allowed it to air dry and blotted off the excess with a kimwipe (Bentley, 2015).
Data and Observations: Below are 3 different pictures of the Hay Infusion culture after the second week. About 1/3 to ½ of the water appears to have evaporated. Compared to last week, the water is slightly less murky, but still not clear. While there is still a distinct odor, the smell is less pungent. The plant matter that we had placed into the sample seems to be largely decomposed.

The following pictures, which are labeled by dilution, are the nutrient agar plates after one week of incubation.

The following pictures, which are labeled by dilution, are the nutrient agar PLU tetracycline plates after one week of incubation.
The table below shows the number of bacteria colonies counted on each plate, corresponding with the serial dilution of each place.

During the lab, we also selected 4 bacteria samples to observe more closely. Our group's observations are shown in the chart below.

Conclusion and Next Steps: Based on the bacteria colony counts, my hypothesis was correct. For example, the 10^-9 nutrient agar plate contained 67 countable colonies, while the 10^-9 nutrient plus tetracycline agar plate contained less, with 30 countable colonies. Tetracycline is used to treat bacterial infections, according to the National Institute of Health (Medline Plus, 2010). I would attribute the differences in our bacteria colony counts, between the nutrient only plates and the nutrient with tetracycline plates, to the presence of tetracycline since it is known to kill bacteria. Tetracycline destroys bacteria by inhibiting enzymes in bacteria cells that are responsible for protein synthesis (Klajn). Tetracycline, when it was first discovered, demonstrated effectiveness against a range of both gram negative and gram positive bacteria (Klajn). However, as antibiotic resistance has become an issue, tetracycline has lost its efficacy against some bacteria and this phenomenon was demonstrated in this lab exercise. While there was less bacterial growth on the plates with tetracycline, there was still growth, indicating that these bacteria may have grown resistant to tetracycline.
Sources:
Bentley, M., Walters-Conte, K., and Nancy K. Zeller. 2015. A Laboratory Manual to Accompany: General Biology II. Department of Biology, American University: Washington D.C.. 23-31.
Klajn, Rafal. n.d. Tetracycline: Chemistry and chemical biology of tetracycline. Institute of Organic Chemistry, Polish Academy of Sciences: Warsaw, Poland. Retrieved from http://www.chm.bris.ac.uk/motm/tetracycline/antimicr.htm.
MedlinePlus. 2010. Tetracycline. National Institute of Health, U.S. National Library of Medicine: Washington, DC. Retrieved from http://www.nlm.nih.gov/medlineplus/druginfo/meds/a682098.html.
Lab 2: Identifying Algae and Protists
Objective: To examine algae and protists from our transect, to understand the characteristics of algae and protists and to practice using a dichatomous key to identify species (Bentley, 2015).
Introduction: This week we examined unicellular eukarya from samples taken from our Hay Infusion, which was prepared the week prior. The goal of the lab was to identify at least three organisms from the "top" of our Hay Infusion and three organisms from the "bottom" of our Hay Infusion, to ensure that we captured organisms that grow and live in different niches. I hypothesized that the organisms found at the "top" of our Hay Infusion would be different from the organisms that were found at the "bottom."

Materials and Methods: We observed the undisturbed Hay Infusion sample through vision and smell. Next, we prepared two wet-mount slides in order to examine the algae and protists present in our sample. To do so, we used a pipette to draw a specimen from the very top surface of the samples and a specimen from the bottom of the jar. To view the organisms, we used a microscope with magnification ranging from 4x to 40x. To identify the particular organisms found, we used a dichotomous key. In order to measure the organisms, we used the microscope's ocular lens.
Observations and Data:
Description of the Hay Infusion: The smell of the sample was rancid and fowl. None of us could bare the smell and there was obvious mold growing on the surface of the, which appeared to have hardened. The bottom of the sample appeared to contain decomposed matter and was almost mud or sand-like. The water within the sample was murky and appeared yellow-brown in color. Of the plant matter that has been placed into the Hay Infusion sample last week (a small Brussels sprout, two pine needles, and a small leaf), only the pine needles appeared intact.

Found Organisms:
From the top of the jar, the following organisms were found;
- Pelomyxa (2mm and motile)
- Paramecium aurella (130 μm and motile)
- Pandorina (colony size: 45 μm and non-motile)



From the bottom of the jar,the following organisms were found;
- Gonium (colony size: 90 μm and non-motile)
- Clopidium (61 μm and motile)
- Paramecium aurella (140 μm and motile)



Conclusion: From the observed data, my hypothesis that there would be different organisms found in the sample from the "top" of the Hay Infusion compared to the organisms found at the "bottom" of the Hay Infusion is not entirely supported. Both niches contained paramecium aurella, and therefore the organisms were not completely different based on the niche. Perhaps paramecium aurella can survive in various niches or perhaps the difference in the "top" and "bottom" of the jar was not too significant. If I were to redo the experiment, I might test chemical properties of the different niches or identify more than 3 organisms from each niche to see if there is more crossover.
Source:
Bentley, M., Walters-Conte, K., and Nancy K. Zeller. 2015. A Laboratory Manual to Accompany: General Biology II. Department of Biology, American University: Washington D.C.. 18.
Lab 1:
Objective:
To make careful observations about the characteristics of different species (Bentley, 2015).
Introduction: In order to achieve the above objective, I have observed a 20x20 ecological niche. My niche is located in the back of campus behind the “North side” residence halls. It is a relatively low traffic part of campus, as people do not regularly travel through the area to get to work, class, or their homes. The transect is part of a community garden on American University’s campus in Washington, DC. Within the transect, there are 4 wooden planters, each containing a different species of vegetation. I hypothesis that the soil/ground sample collected from the community garden will contain many species because of the varied factors within this niche.
Materials and Methods: To complete these observations, my group members and I walked to the transect and took notes using a pencil, paper, and a Smartphone’s camera (pictures below). We spent about 15 minutes collecting visual observations and also collected a soil/ground specimen using a 50mL conical tube. The specimen collected from within the 20x20 transect was used to conduct a Hay Infusion. Completing the Hay Infusion involved combining 500mL of water with 10-12g of the soil/vegetation/fecal specimen in a jar. 0.1g of dried milk was added to the mixture and mixed gently for 10 seconds. The jar was left unopened for a week to allow Protista to grow (Bentley, 2015).
Observations and Data:
The abiotic factors include:
• Direct sunlight, as there is no vegetation or constructed object to provide shade
• Frozen soil, due to recent temperatures
• Frost and ice on the plants, due to recent weather and temperatures
• 4 constructed 3x6 rectangular vegetation planters
• Fence: the area is fenced in, which provides protect from larger animals that may eat the growing vegetation
The biotic factors include:
• Woodchips surrounding the vegetation boxes
• Dried out grass and weeds surrounding the vegetation boxes
• Animal feces
• Decomposing plant matter in and around the vegetation boxes
• Vegetation variation of the planters (kale, cucumber, lettuce, and Brussels sprouts)
Conclusion: Based on our observations, there are many biotic and abiotic factors that influence this 20x20 niche. While I could visibly see multiple species of vegetation, I could not observe multiple species of bacteria or protista without a microscope. Next lab, we will use the Hay Infusion sample to look at organisms from out transect under the microscope. Perhaps, we will identify more species.
MP
Sources:
Bentley, M., Walters-Conte, K., and Nancy K. Zeller. 2015. A Laboratory Manual to Accompany: General Biology II. Department of Biology, American University: Washington D.C.. 16-17.


